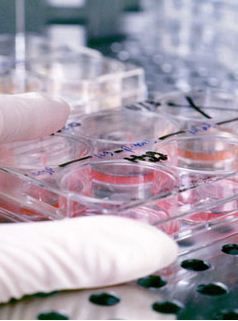

Directorio
Oficina de Transferencia de Conocimiento (OTC)
- Vicegerencia de Investigación y Transferencia
- Acceso a su Web
- Centro de Investigación y Transferencia Complutense
Facultad de Medicina
Edificio Entrepabellones 7 y 8
Calle del Doctor Severo Ochoa, 7, 2ª planta
Ciudad Universitaria
28040 Madrid. - otri@ucm.es
- 91 394 6439
- Ciudad Universitaria
- G,U,82,132 ____ Aparcamiento público
- De lunes a viernes de 8:00 a 15:00 h.